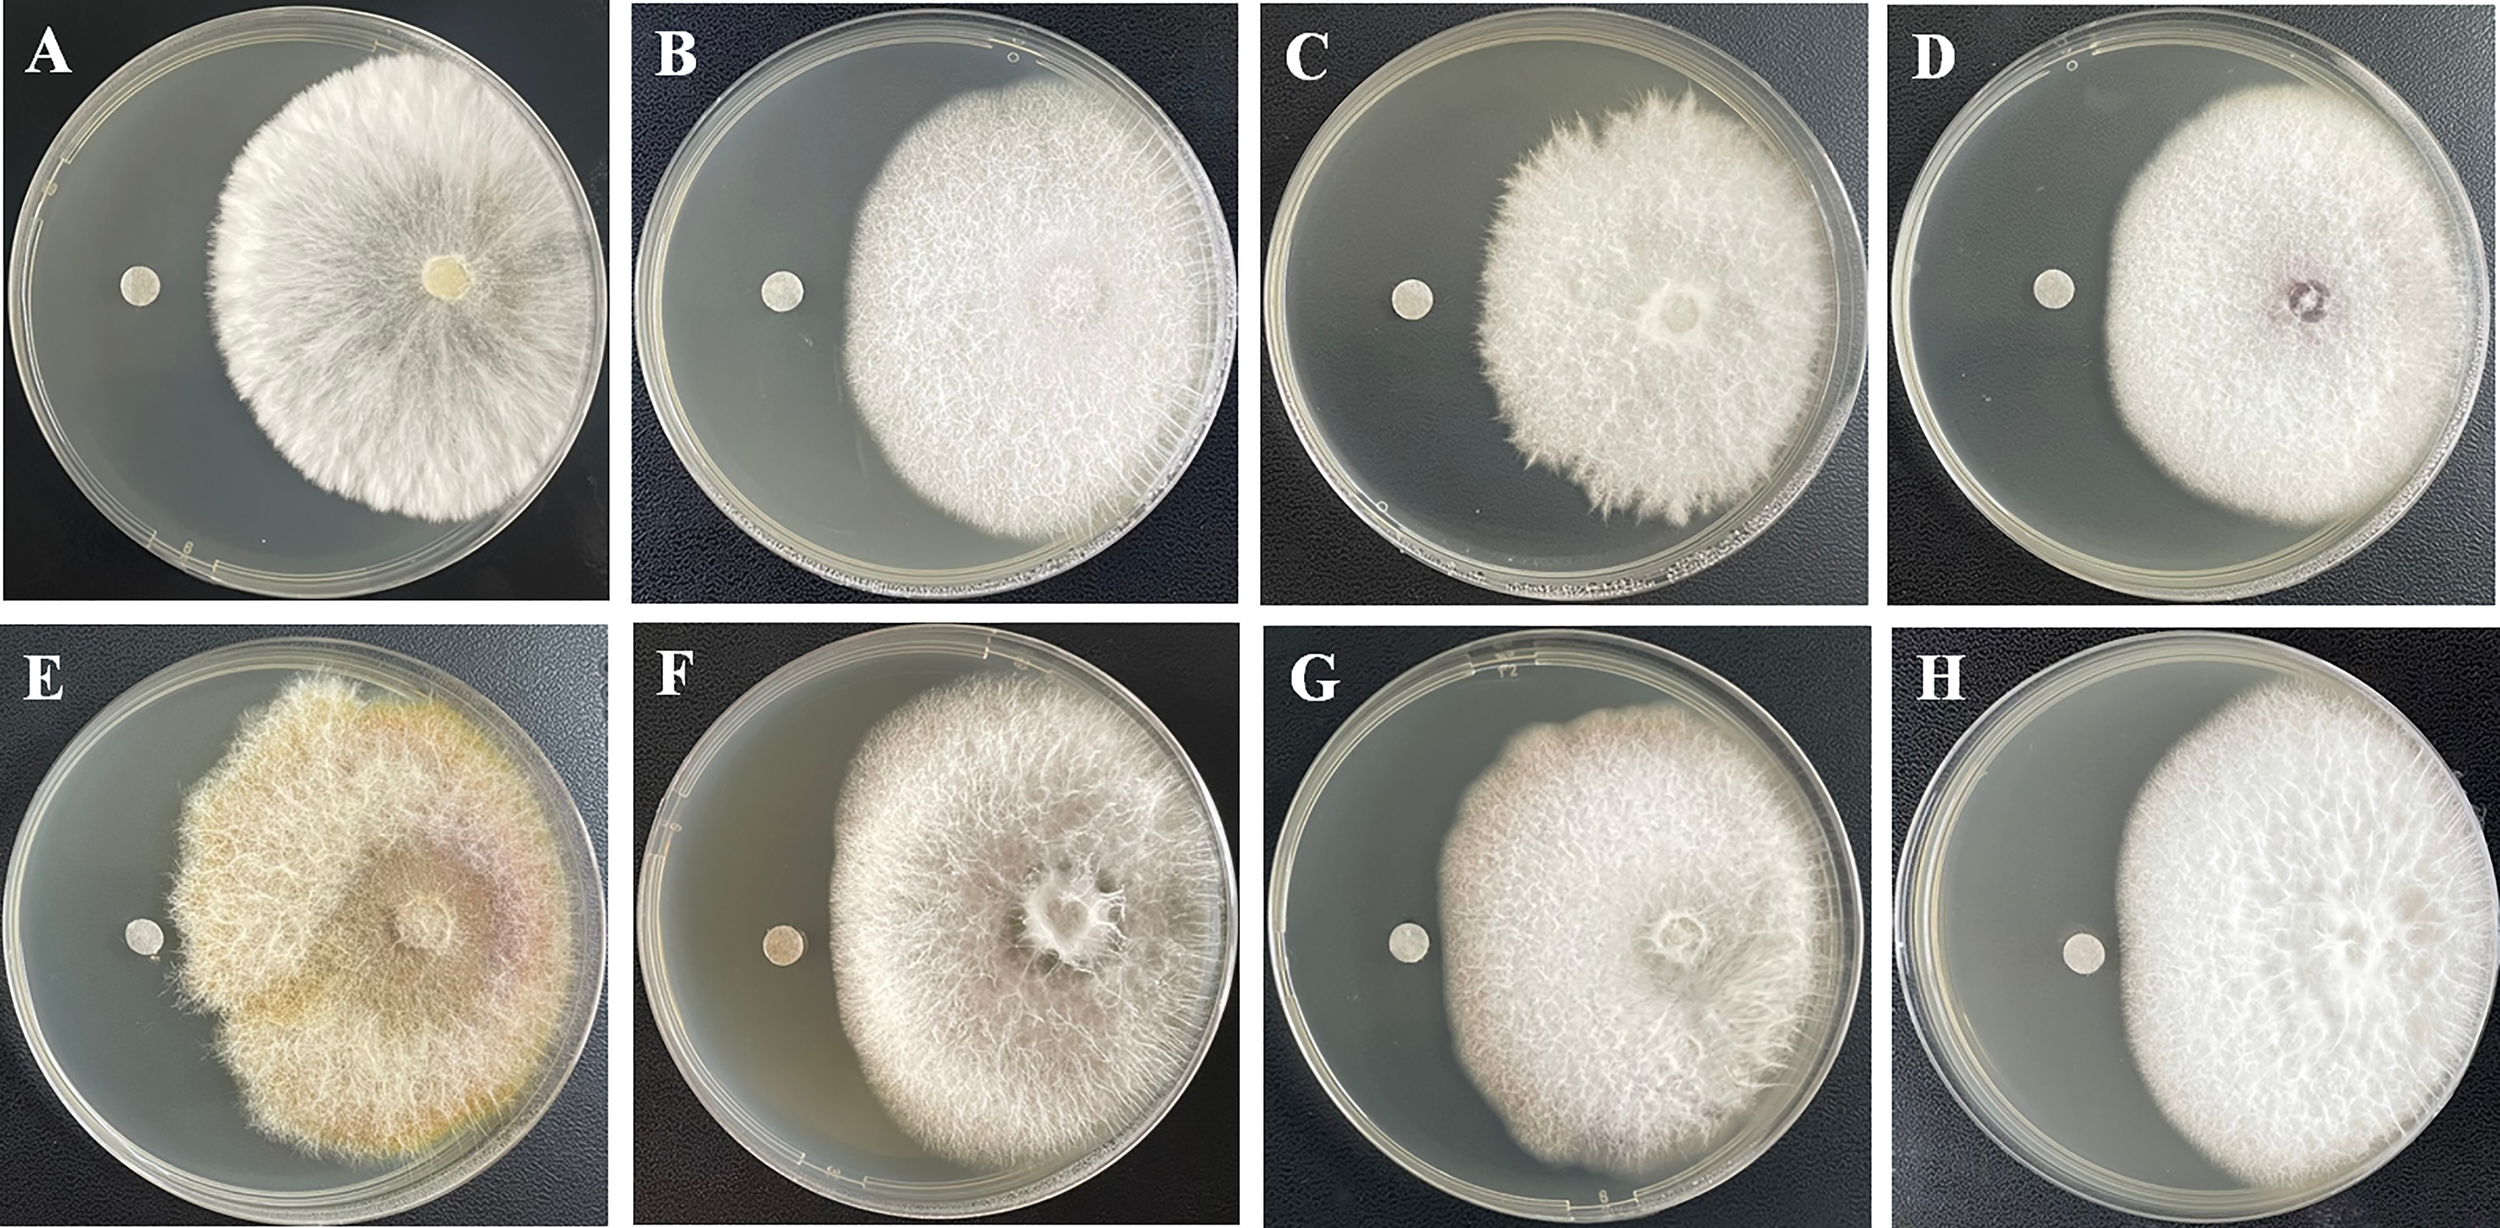

Abstract
Marine natural products, characterized by fascinating drug-like functionalities and promising biological activities, are important base materials for innovative drugs and agrochemicals. Chemical investigations of the marine-algal-derived endophytic fungus Aspergillus sp. 1022LEF residing in the inner tissue of marine red alga yielded a novel polyketide-terpene hybrid metabolite, namely tennessenoid A (1), as well as six known biosynthetic congeners including two steroids, ergosta-4,6,8(14),22-tetraen-3-one (2) and (22E,24R)-3α-ureido-ergosta-4,6,8(14),22-tetraene (3), and four sorbicillinoid-based compounds, saturnispol G (4), trichodimerol (5), and dihydrotrichodimer ethers A and B (6 and 7). Their structures were unambiguously determined based on extensive 1D/2D NMR and HRESIMS spectroscopic analyses. Tennessenoid A (1) was characterized as an unprecedented steroid−sorbicillinoid adduct via a C−C bond, which was rarely-observed in natural products. All of the isolated compounds were evaluated for their antifungal activities against eight plant pathogenetic fungi. 1, in particular, demonstrated broad-spectrum activities against Sclerotium rolfsii Sacc., Fusarium oxysporum (Schl.) F.sp cucumerinum Owen, Coniella diplodiella Petrak et Sydow, Physalospora piricola Nose., Fusarium graminearum schw., Alternaria mali rob., Colletotrichum orbiculare Arx., and Alternaria porri (E11iott) Cifed., with the inhibition zone diameters ranging from 2 to 7 mm.
Introduction
Natural products, which possessed attractive structures and potent bioactivities, traditionally contributed significantly in the development of new innovative drugs and agrochemicals (Butler, 2005). Since the first broad-spectrum antibiotic agent penicillin has been discovered as early as 1928, the “Golden Age of Antibiotics” was sparked in the last century (Knight et al., 2003; Zhang et al., 2020). From then on, the tendency in searching for new natural-product-based drugs is uptapped. It is estimated that over half (> 60%) of approved therapeutic agents are derived from natural products or their derivatives covering the period 1981 to 2019 (Newman and Cragg, 2020). Among them, microbial natural products, also known as secondary metabolites or specialised metabolites, have played nonnegligible and irreplaceable role (Knight et al., 2003). More than 20,000 microbial natural products, which offered incomparable chemical diversity with structural complexity and biological potency, have been described (Li et al., 2018a). Nowadays, along with the rapid development of new technologies such as functional genomics, the burgeoning microbial natural products-based drug discoveries for pharmaceutical and agrochemical applications are in a revolutionary period. Meanwhile, in spite of outstanding developments in microbial natural products over the last few years, there is still an insistent necessity for searching for more interesting microbial natural products, especially those from extreme and unexplored environments.
Marine microorganisms are one of the most notable and prolific sources of bioactive natural products (Carroll et al., 2021). Although a large amount of natural products have been discovered from marine microorganisms (Rateb and Ebel, 2011; Zhang et al., 2020), it is a matter of fact that, the trend towards finding new natural products is approaching saturation due to the redundancy of the isolation and characterization of both microorganisms and biosynthetic pathways. Consequently, the discovery of new compounds from unexplored environments has proven to be an alternative strategy for the sake of pursuing for microbial novelty (Soldatou and Baker, 2017). Marine-derived endophytic fungi residing in marine alga and mangroves are extraordinary adapted and metabolically active under extreme environmental conditions, which promote them to produce abundant novel secondary metabolites (El-Bondkly et al., 2021).
As part of our ongoing research on bioactive secondary metabolites from marine-derived endophytic fungi (Zhao et al., 2018; Yuan et al., 2020; Zhao et al., 2020), the fungal strain Aspergillus sp. 1022LEF isolated from the inner tissue of the marine red alga Grateloupia turuturu was selected for a detailed chemical investigation. A scaled-up fermentation and subsequent chromatographic purification yielded a novel polyketide-terpene hybrid metabolite tennessenoid A (1) and six known biosynthetic congeners including two steroids (2 and 3) and four sorbicillinoid-based compounds (4−7) (Figure 1). The newly-discovered tennessenoid A (1) was characterized as an unprecedented steroid−sorbicillinoid adduct via a C−C bond, which was rarely-observed in natural products. Furthermore, compound 1 demonstrated broad-spectrum antifungal activity against eight plant pathogenetic fungi [Sclerotium rolfsii Sacc., Fusarium oxysporum (Schl.) F.sp cucumerinum Owen, Coniella diplodiella Petrak et Sydow, Physalospora piricola Nose., Fusarium graminearum schw., Alternaria mali rob., Colletotrichum orbiculare Arx., and Alternaria porri (E11iott) Cifed.], which highlighted its potential as an antifungal agrochemical in agriculture. Herein we report the isolation, structural elucidation, and antifungal activities of the isolated compounds.
Figure 1

Chemical structures of compounds 1–7.
Materials and Methods
General Experimental Procedures
Optical rotations data were measured by a Jasco P-1020 digital polarimeter (Jasco, Tokyo, Japan) with MeOH as solvent. UV spectra were obtained on a Shimadzu UV-2700 spectrophotometer (Shimadzu, Kyoto, Japan). NMR spectra were recorded on an Agilent DD2 NMR spectrometer (Agilent Technologies, Santa Clara, CA, United States) operating at 500 MHz for the 1H channel and 125 MHz for the 13C channel. HRESIMS data were acquired on a Waters ACQUITY UPLC I-Class-Vion IMS Q-TOF mass spectrometer (Waters Corp., Massachusetts, U.S.A.). Column chromatography was carried out with silica gel (200−300 mesh, Haiyang Chemical Factory, Qingdao, China), Lobar LiChroprep RP-18 (40−60 μm, Merck, Darmstadt, Germany), and Sephadex LH-20 (Merck). All solvents used for extraction and purification were of analytical grade for column chromatography, or of HPLC grade for HPLC analysis. Precoated silica gel plates were used for thin-layer chromatography (TLC) with detection at 254 nm, while preparative TLC was performed with precoated TLC plates (GF254, Haiyang Chemical Factory).
Fungal Material
Following standard procedures (Li et al., 2018b), the endophytic fungal strain 1022LEF was isolated from the inner tissue of the marine red alga Grateloupia turuturu, which was collected from Qingdao, China. It was preliminary identified as Aspergillus sp. by comparing the sequence of the ITS region of the rDNA. The ITS sequence of the isolated fungus was 99% identical to that of Aspergillus sp. (GenBank accession: MK605984.1). The GenBank number of MH785494 was assigned to this fungal strain. This fungus was deposited in Tobacco Research Institute of Chinese Academy of Agricultural Sciences with a deposition number of 1022LEF.
Fermentation, Extraction, and Purification
The fungus Aspergillus sp. 1022LEF was statically cultured at 28°C in 150 × 1 L Erlenmeyer flasks, each containing 300 mL of potato dextrose broth medium (Solarbio Life Sciences CO., LTD., Beijing, China). Following fermentation for 50 days, the cultures were collected and filtered to separate the broth and mycelia. The broth and the crushed mycelia were extracted with EtOAc. Then, the separate EtOAc extracts were combined and evaporated to give 18.6 g of residue. Detailed separation process was as follows: (i) The resulting residue was subjected to silica gel vacuum liquid chromatography with a stepwise PE/EtOAc (30:1→1:1, v/v) and CH2Cl2/MeOH (20:1→1:1, v/v) mixture systems to afford four major fractions A−D. (ii) Fraction A eluting with PE/EtOAc 2:1 was purified by silica gel column chromatography (CC) (CH2Cl2/MeOH, 30:1→10:1, v/v) to yield the new compound 1 (5.8 mg). (iii) Compounds 2 (6.2 mg) and 3 (4.6 mg) were obtained from fraction B eluting with PE/EtOAc 1:1 by preparative TLC (plate: 20 × 20 cm; developing solvents: CH2Cl2/MeOH 30:1). (iv) Fraction C eluting with CH2Cl2/MeOH 20:1 was refractionated by reversed-phase C18 CC with a mixture of MeOH/H2O system (1:9→10:0, v/v) to give five subfractions (Fraction C-1−C-5). Fraction C-1 was subjected to Sephadex LH-20 (MeOH) to yield 5 (8.9 mg). Fraction C-3 was further purified by silica gel CC (CH2Cl2/MeOH, 30:1→10:1, v/v), and followed by Sephadex LH-20 (MeOH) to give 6 (10.2 mg) and 7 (9.0 mg). Finally, compound 4 (11.6 mg) was separated from fraction C-4 via preparative TLC (plate: 20 × 20 cm; developing solvents: CH2Cl2/MeOH 20:1).
Tennessenoid A (1): amorphous powder; +15.6 (c 0.10, MeOH); UV (MeOH) λmax (log ϵ) 201 (3.29), 268 (3.05), 290 (4.19), 305 (3.10) nm; 1H and 13C NMR data (measured in CDCl3), see Table 1; HRESIMS m/z 665.4183 [M + Na]+ (calcd for C42H58O5Na, 665.4182).
Table 1
| No. | δ H (J in Hz) | δ C, type | No. | δ H (J in Hz) | δ C, type |
|---|---|---|---|---|---|
| 1 | 1.75, m; 1.31, m | 34.4, CH2 | 22 | 5.19, d (15.1, 7.8) | 135.3, CH |
| 2 | 1.77, m; 1.73, m | 20.8, CH2 | 23 | 5.24, d (15.1, 6.8) | 132.2, CH |
| 3 | 2.69, m | 43.8, CH | 24 | 1.87, m | 42.9, CH |
| 4 | 5.31, br s | 119.9, CH | 25 | 1.47, m | 33.1, CH |
| 5 | 146.8, C | 26 | 0.82, d (5.9) | 19.7, CH3 | |
| 6 | 5.84, d (9.6) | 125.9, CH | 27 | 0.84, d (5.9) | 20.0, CH3 |
| 7 | 6.13, d (9.6) | 125.6, CH | 28 | 0.92, d (5.8) | 17.6, CH3 |
| 8 | 124.7, C | 1′ | 176.2, C | ||
| 9 | 1.93, m | 45.3, CH | 2′ | 52.7, C | |
| 10 | 35.6, C | 3′ | 214.6, C | ||
| 11 | 1.60, m; 1.56, m | 19.3, CH2 | 4′ | 89.6, C | |
| 12 | 2.01, m; 1.25, m | 36.4, CH2 | 5′ | 4.35, br d (10.4) | 72.5, CH |
| 13 | 43.6, C | 6′ | 3.02, dd (17.5, 10.4); 2.79, d (17.5) | 40.3, CH2 | |
| 14 | 149.7, C | 7′ | 199.2, C | ||
| 15 | 2.39, m; 2.29, m | 25.0, CH2 | 8′ | 6.05, d (15.7) | 127.2, CH |
| 16 | 1.77, m; 1.44, m | 27.9, CH2 | 9′ | 7.18, dd (15.7, 10.1) | 144.7, CH |
| 17 | 1.20, m | 55.9, CH | 10′ | 6.20, dd (15.6, 10.1) | 130.0, CH |
| 18 | 0.92, s | 19.2, CH3 | 11′ | 6.27, dq (15.6, 6.4) | 142.2, CH |
| 19 | 0.81, s | 18.6, CH3 | 12′ | 1.89, d (6.4) | 18.9, CH3 |
| 20 | 2.11, m | 39.4, CH | 13′ | 1.48, s | 18.4, CH3 |
| 21 | 1.04, d (6.6) | 21.2, CH3 | 14′ | 1.41, s | 16.5, CH3 |
1H NMR (500 MHz, δ in ppm) and 13C NMR Data (125 MHz, δ in ppm) for 1 (measured in CDCl3).
Antifungal Assay
Antifungal activity of compounds 1−8 was evaluated by modified agar diffusion test method (Ahmed et al., 2011). The test compounds were dissolved in acetone at a concentration of 1 mg/mL, and then were made up to a final concentration of 20 μg/mL. The solution was transferred to a sterile filter disk (each 50 μL), which was placed on the agar growth medium for the test pathogenetic fungi. Fungal diseases commonly found in agriculture, Sclerotium rolfsii Sacc., Fusarium oxysporum (Schl.) F.sp cucumerinum Owen, Coniella diplodiella Petrak et Sydow, Physalospora piricola Nose., Fusarium graminearum schw., Alternaria mali rob., Colletotrichum orbiculare Arx., and Alternaria porri (E11iott) Cifed., were chosen as the test pathogenetic fungi. The radius of the zone of inhibition was measured in millimeters starting at the middle of the filter. Prochloraz was used as the positive control.
Results and Discussion
Structural Elucidation of the Isolated Compounds
Tennessenoid A (1) was isolated as an amorphous powder. The molecular formula of 1 was determined to be C42H58O5 by observation of the [M + Na]+ ion peak in the HRESIMS spectrum at m/z 665.4183 (calcd for C42H58O5Na, 665.4182). The 13C NMR spectrum of 1 (Table 1) revealed 42 carbon resonances, which were classified into two ketone carbonyls at δC 214.6 (C-3′) and 199.2 (C-7′), one ester carbonyl at δC 176.2 (C-1′), seven quaternary carbons including three sp2 and one oxygenated at δC 89.6 (C-4′), 16 methines including nine olefinic at δC 127.2 (C-8′), 144.7 (C-9′), 130.0 (C-10′), 142.2 (C-11′), 119.9 (C-4), 125.9 (C-6), 125.6 (C-7), 135.3 (C-22), and 132.2 (C-23) and one oxygenated at δC 72.5 (C-5′), seven methylenes, and nine methyl groups with the aid of DEPT spectra. The 1H NMR data of 1 (Table 1) displayed signals for nine methyl groups [including five doublets at δH 1.89 (d, J = 6.4 Hz), 1.04 (d, J = 6.6 Hz), 0.92 (d, J = 5.8 Hz), 0.84 (d, J = 5.9 Hz), 0.82 (d, J = 5.9 Hz), and four singlets at δH 1.48, 1.41, 0.92, and 0.81], nine olefinic protons (from δH 5.19 to 7.18), and a series of indistinguishable aliphatic multiplets. Further analysis of the 1D and 2D NMR data allowed for the establishment of fragments 1A and 1B for compound 1 (Figure 2).
Figure 2

Key 1H-1H COSY (bold lines) and HMBC (red and blue arrows for intra- and inter-fragments 1A and 1B, respectively) correlations of 1.
Interpretation of the 2D NMR data (1H−1H COSY and HMBC cross-peaks) of fragment 1A, two spin-coupling systems, H-8′/H-9′/H-10′/H-11′/H3-12′ and H-5′/H2-6′, were readily established. The connectivities of these spin systems, the ketone/ester carbonyls, and the methyls were achieved by analysis of the key HMBC correlations (Figure 2). The HMBC correlations from H3-14′ to C-1′/C-3′ and from H3-13′ to C-3′/C-4′generated a furan lactone moiety and it was linked to C-5′ by HMBCs from H-5′ to C-3′ and H3-13′ to C-5′. Fragment 1A was deduced to be a vertinolide derivative, a sorbicillinoid-type polyketide isolated from the endophytic fungus Clonostachys rosea B5-2 (Supratman et al., 2021).
Fragment 1B was deduced as a steroid moiety by analysis of characteristic signals in 1D and 2D NMR spectrum. A combination of 1H−1H COSY and HMBC correlations (Figure 2) enabled us to identify the (22E)-ergosta-4,6,8(14),22-tetraene nucleus, which was similar to compounds 2 and 3. Moreover, the connection between fragments 1A and 1Bvia the C−C bond was established by the diagnostic HMBC correlations from H3-14′ to C-3 and from H-3 to C-1′ (Figure 2). Accordingly, the planar structure of 1 was determined.
The relative stereochemistry of 1 was established by interpretation of NOESY spectrum. As for fragment 1A, the mutual NOE correlations of H-5′/H3-13′/H3-14′ indicated a cofacial relationship among H-5′, H3-13′, and H3-14′ (Figure 3). In fragment 1B, NOE correlations between H3-19 and H-11a, between H-11a/H3-18, and between H3-18 and H-15a/H-20 suggested that these groups were located at the same side of the 6/6/6/5 tetracyclic nucleus, while on the contrary, NOE correlation between H-17 and H-15b indicated they oriented towards opposite side (Figure 3). This deduction was also in consistance with the reported ergosteroids 2 and 3. The β-orientations of H-20 and H-24 were deduced by biosynthesis considerations based on those in 2 and 3. Furthermore, the coupling constants between H-8′ and H-9′ (J = 15.7 Hz) and between H-10′ and H-11′ (J = 15.7 Hz) illustrated that the double bonds at C-8’ and C-10’ were in the E configurations. However, since fragments 1A and 1B can be rotated freely, the high flexibility made the relative configurations of 1A and 1B unsolved, as well as the absolute configurations. Many attempts to cultivate single crystals which were suitable for X-ray diffraction analysis in mixed solvent systems (MeOH/H2O, CH2Cl2/H2O, acetone/H2O, etc.) were tried. However, they all failed unfortunately.
Figure 3

NOESY correlations of 1.
In addition, six known biosynthetic congeners including two steroids, ergosta-4,6,8(14),22-tetraen-3-one (2) (Fujimoto et al., 2004) and (22E,24R)-3α-ureido-ergosta-4,6,8(14),22-tetraene (3) (Yoshikawa et al., 2001), and four sorbicillinoid-based compounds, saturnispol G (4) (Meng et al., 2018), trichodimerol (5) (Zhai et al., 2016), and dihydrotrichodimer ethers A and B (6 and 7) (Zhai et al., 2016) were isolated and identified by comparison of the spectroscopic data with those reported in the literatures. Compound 1 was characterized as an unprecedented steroid−sorbicillinoid adduct, while compounds 5−7 were previously reported bisorbicillinoids. The putative biosynthesis of 1 can be traced back to vertinolide and ergosteroid (Figure 4). The aldolization of 2 and vertinolide generated the unique C−C bond, which was rarely-observed in natural ergosteroids, while dimerization of vertinolide formed dimers 5−7.
Figure 4

Proposed biosynthetic pathway of 1 and related compounds.
Antifungal Activity
The isolated compounds 1−8 were evaluated to determine their antifungal activity against eight pathogenetic fungi. As a result, the new compound 1, in particular, exhibited modest but broad-spectrum activities against S. rolfsii, F. oxysporum, C. diplodiella, P. piricola, F. graminearum, A. mali, C. orbiculare, and A. porri, with the radius of the inhibition zone of 7, 5, 5, 5, 3, 3, 2, and 2 mm, respectively (Figure 5), while the radius of the inhibition zone of the positive control prochloraz were ranging from 7 to 12 mm. Sorbicillinoids are a family of hexaketide secondary metabolites with a characteristic sorbyl side chain residue. Previous studies reported sorbicillinoids possessed high antimicrobial activity and can be used as a biological control agent (Zhai et al., 2016). Moreover, sorbicillinoids are also found to potently inhibit fungal pathogens both in vitro and in vivo. Bisvertinolone, a bisorbicillinoid produced by Trichoderma longibrachiatum SFC100166, not only showed considerable activity against phytopathogenic fungi Cladosporium coccodes, Colletotrichum coccodes, Cylindrocarpon destructans, Magnaporthe oyrzae, and Phytopathora infestans, with MIC values ranging from 6.3 to 100 μg/mL, but also reduced the development of tomato late blight disease strongly (Ngo et al., 2021). Further studies such as in vivo assay and mode of action of antifungal activities may reveal the potential of the newly-isolated steroid−sorbicillinoid adduct 1 as an antifungal agrochemical in agriculture.
Figure 5
Antifungal activities of 1 against eight plant pathogenetic fungi−S. rolfsii(A), F. oxysporum(B), C. diplodiella(C), P. piricola(D), F. graminearum(E), A. mali(F), C. orbiculare(G), and A. porri(H).
Conclusions
In conclusion, a novel polyketide-terpene hybrid metabolite, tennessenoid A (1), as well as six known biosynthetic congeners, ergosta-4,6,8(14),22-tetraen-3-one (2), (22E,24R)-3α-ureido-ergosta-4,6,8(14),22-tetraene (3), saturnispol G (4), trichodimerol (5), and dihydrotrichodimer ethers A and B (6 and 7) were isolated from the marine-derived endophyte of Aspergillus sp. 1022LEF. Their structures were determined by detailed analysis of NMR data and HRESIMS. The steroids 2−3 and the sorbicillinoids 4−7 were common fungal secondary metabolites, whereas the new compound 1 represented the first example of steroid−sorbicillinoid adduct via a C−C bond. Moreover, this unprecedented compound exhibited broad-spectrum antifungal activities against several plant pathogenetic fungi. This study indicated that the marine-derived microbes were considered to be valuable resources for the development of new agrochemicals.
Funding
This work was supported by the Central Public-interest Scientific Institution Basal Research Fund (Y2022QC32 and Y2021XK25) and the Agricultural Science and Technology Innovation Program (ASTIP-TRIC05).
Publisher’s Note
All claims expressed in this article are solely those of the authors and do not necessarily represent those of their affiliated organizations, or those of the publisher, the editors and the reviewers. Any product that may be evaluated in this article, or claim that may be made by its manufacturer, is not guaranteed or endorsed by the publisher.
Statements
Data availability statement
The original contributions presented in the study are included in the article/Supplementary Material. Further inquiries can be directed to the corresponding author.
Author contributions
Experiment implementation, D-LZ and H-SW. Writing—original draft preparation, D-LZ and L-WG. Writing—review and editing, PZ. All authors have read and approved the final manuscript.
Conflict of interest
The authors declare that the research was conducted in the absence of any commercial or financial relationships that could be construed as a potential conflict of interest.
Supplementary material
The Supplementary Material for this article can be found online at: https://www.frontiersin.org/articles/10.3389/fmars.2022.923128/full#supplementary-material
References
1
Ahmed I. Hussain H. Schulz B. Draeger S. Padula D. Pescitelli G. et al . (2011). Three New Antimicrobial Metabolites From the Endophytic Fungus Phomopsis Sp. Eur. J. Org. Chem.2011, 2867–2873. doi: 10.1002/ejoc.201100158
2
Butler M. S. (2005). Natural Products to Drugs: Natural Product Derived Compounds in Clinical Trials. Nat. Prod. Rep.22, 162–195. doi: 10.1039/b402985m
3
Carroll A. R. Copp B. R. Davis R. A. Keyzers R. A. Prinsep M. R. (2021). Marine Natural Products. Nat. Prod. Rep.38, 362–413. doi: 10.1039/D0NP00089B
4
El-Bondkly E. A. M. El-Bondkly A. A. M. El-Bondkly A. A. M. (2021). Marine Endophytic Fungal Metabolites: A Whole New World of Pharmaceutical Therapy Exploration. Heliyon7, e06362. doi: 10.1016/j.heliyon.2021.e06362
5
Fujimoto H. Nakamura E. Okuyama E. Ishibashi M. (2004). Six Immunosuppressive Features From an Ascomycete, Zopfiella Longicaudata, Found in a Screening Study Monitored by Immunomodulatory Activity. Chem. Pharm. Bull.52, 1005–1008. doi: 10.1248/cpb.52.1005
6
Knight V. Sanglier J. J. DiTullio D. Braccili S. Bonner P. Waters J. et al . (2003). Diversifying Microbial Natural Products for Drug Discovery. Appl. Microbiol. Biotechnol.62, 446–458. doi: 10.1007/s00253-003-1381-9
7
Li Z. X. Wang X. F. Ren G. W. Yuan X. L. Deng N. Ji G. X. et al . (2018b). Prenylated Diphenyl Ethers From the Marine Algal-Derived Endophytic Fungus Aspergillus Tennesseensis. Molecules23, 2368. doi: 10.3390/molecules23092368
8
Li Z. Zhu D. Shen Y. (2018a). Discovery of Novel Bioactive Natural Products Driven by Genome Mining. Drug Discov. Ther.12, 318–328. doi: 10.5582/ddt.2018.01066
9
Meng J. Cheng W. Heydari H. Wang B. Zhu K. Konuklugil B. et al . (2018). Sorbicillinoid-Based Metabolites From a Sponge-Derived Fungus Trichoderma Saturnisporum. Mar. Drugs16, 226. doi: 10.3390/md16070226
10
Newman D. J. Cragg G. M. (2020). Natural Products as Sources of New Drugs Over the Nearly Four Decades From 01/1981 to 09/2019. J. Nat. Prod.83, 770–803. doi: 10.1021/acs.jnatprod.9b01285
11
Ngo M. T. Nguyen M. V. Han J. W. Park M. S. Kim H. Choi G. J. (2021). In Vitro and In Vivo Antifungal Activity of Sorbicillinoids Produced by Trichoderma Longibrachiatum. J. Fungi7, 428. doi: 10.3390/jof7060428
12
Rateb M. E. M. Ebel R. (2011). Secondary Metabolites of Fungi From Marine Habitats. Nat. Prod. Rep.28, 290. doi: 10.1039/c0np00061b
13
Soldatou S. Baker B. J. (2017). Cold-Water Marine Natural Products 2006 to 2016. Nat. Prod. Rep.34, 585–626. doi: 10.1039/C6NP00127K
14
Supratman U. Suzuki T. Nakamura T. Yokoyama Y. Harneti D. Maharani R. et al . (2021). New Metabolites Produced by Endophyte Clonostachys Rosea B5-2. Nat. Prod. Res.35, 1525–1531. doi: 10.1080/14786419.2019.1656629
15
Yoshikawa K. Ikuta M. Arihara S. Matsumura E. Katayama S. (2001). Two New Steroidal Derivatives From the Fruit Body of Chlorophyllum Molybdites. Chem. Pharm. Bull.49, 1030–1032. doi: 10.1248/cpb.49.1030
16
Yuan X. L. Wang X. F. Xu K. Li W. Chen D. Zhang P. (2020). Characterization of a New Insecticidal Anthraquinone Derivative From an Endophyte of Acremonium Vitellinum Against Helicoverpa Armigera. J. Agric. Food Chem.68, 11480–11487. doi: 10.1021/acs.jafc.0c05680
17
Zhai M. M. Qi F. M. Li J. Jiang C. X. Hou Y. Shi Y. P. et al . (2016). Isolation of Secondary Metabolites From the Soil-Derived Fungus Clonostachys Rosea YRS-06, a Biological Control Agent, and Evaluation of Antibacterial Activity. J. Agric. Food Chem.64, 2298–2306. doi: 10.1021/acs.jafc.6b00556
18
Zhang P. Wei Q. Yuan X. Xu K. (2020). Newly Reported Alkaloids Produced by Marine-Derived Penicillium Species (Covering 2014–2018). Bioorg. Chem.99, 103840. doi: 10.1016/j.bioorg.2020.103840
19
Zhao D. L. Han X. B. Wang M. Zeng Y. T. Li Y. Q. Ma G. Y. et al . (2020). Herbicidal and Antifungal Xanthone Derivatives From the Alga-Derived Fungus Aspergillus Versicolor D5. J. Agric. Food Chem.68, 11207–11214. doi: 10.1021/acs.jafc.0c04265
20
Zhao D. L. Yuan X. L. Du Y. M. Zhang Z. F. Zhang P. (2018). Benzophenone Derivatives From an Algal-Endophytic Isolate of Penicillium Chrysogenum and Their Cytotoxicity. Molecules23, 3378. doi: 10.3390/molecules23123378
Summary
Keywords
steroids, sorbicillinoids, marine fungus, Aspergillus , antifungal activity
Citation
Zhao D-L, Wang H-S, Gao L-W and Zhang P (2022) Tennessenoid A, an Unprecedented Steroid−Sorbicillinoid Adduct From the Marine-Derived Endophyte of Aspergillus sp. Strain 1022LEF. Front. Mar. Sci. 9:923128. doi: 10.3389/fmars.2022.923128
Received
18 April 2022
Accepted
28 April 2022
Published
26 May 2022
Volume
9 - 2022
Edited by
Shan He, Ningbo University, China
Reviewed by
Weiyi Wang, State Oceanic Administration, China; Tingting Wang, Ningbo University, China
Updates
Copyright
© 2022 Zhao, Wang, Gao and Zhang.
This is an open-access article distributed under the terms of the Creative Commons Attribution License (CC BY). The use, distribution or reproduction in other forums is permitted, provided the original author(s) and the copyright owner(s) are credited and that the original publication in this journal is cited, in accordance with accepted academic practice. No use, distribution or reproduction is permitted which does not comply with these terms.
*Correspondence: Peng Zhang, zhangpeng@caas.cn
†These authors have contributed equally to this work
This article was submitted to Aquatic Microbiology, a section of the journal Frontiers in Marine Science
Disclaimer
All claims expressed in this article are solely those of the authors and do not necessarily represent those of their affiliated organizations, or those of the publisher, the editors and the reviewers. Any product that may be evaluated in this article or claim that may be made by its manufacturer is not guaranteed or endorsed by the publisher.